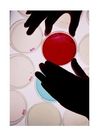

Alvim Srl applications
In industrial cooling towers, bacterial growth on surfaces (biofilm) causes serious problems, both contributing to the deterioration of materials and, most important, increasing the risk of harmful microbiological contaminations (e.g. Legionella pneumophila). For these reasons, large amounts of chemical substances (biocides) are used to limit microbiological growth in such systems.
In industrial cooling towers, biofilm growth can cause serious problems, both contributing to the deterioration of materials and, most important, increasing the risk of harmful microbiological contaminations (e.g. Legionella). For these reasons, large amounts of chemical substances (biocides) are used to limit microbiological growth in such systems. The manager of this cooling tower planned to automatically dose chlorine continuously (24/7) in the water; later on, he decided to install an ALVIM probe in the plant, to check the effectiveness of the treatment.
In a heat exchanger, a major component of any power plant, a 20 microns thick bacterial layer (biofilm) can cause a 30% decrease in thermal efficiency: biofilm, indeed, is up to 4 times more insulating than calcium carbonate scale. Moreover, biofilm can increase inorganic fouling, producing sticky substances that increase particles adhesion. For these reasons, large amounts of chemical substances (biocides) are used to limit microbiological growth in such systems. The manager of this power plant decided to install an ALVIM Biofilm Monitoring System, in order to verify that the biocide treatment (chlorination, in this case) was effective in removing the bacteria settled inside the cooling water system.
Even when it has not been created by pathogenic bacteria, biofilm is the ideal environment for the survival and growth of pathogens, includingLegionella pneumophila. It is well known that such bacteria do not usually form biofilms by themselves, but they are commonly found in biofilms made by other bacteria. This kind of environment greatly increases Legionella possibility of survival and growth. Thus, the best way to prevent Legionella outbreaks is limiting biofilm development.